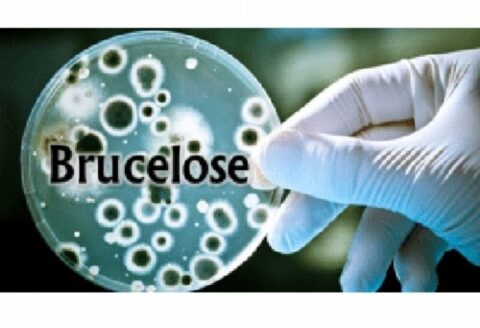

L’Égypte envisage d’adopter une loi réglementant la location de ses hôpitaux publics à des opérateurs étrangers, dans le but de moderniser son système de santé tout en garantissant un accès gratuit aux soins pour ses citoyens. Ce projet de réforme, qui inclut une proposition du Qatar pour gérer l’Institut national du cancer à Sheikh Zayed, vise à attirer l’expertise médicale internationale pour moderniser des infrastructures souvent obsolètes. Le gouvernement égyptien cherche ainsi à renforcer la qualité des soins tout en maintenant l’accès pour les populations les plus démunies.
Le projet est actuellement en cours d’étude, et le gouvernement a assuré que les traitements pour les citoyens égyptiens resteraient majoritairement gratuits. Quant aux préoccupations concernant les employés, le Premier ministre, Moustafa Madbouly, a précisé qu’il n’y aurait pas de licenciements, mais plutôt un redéploiement du personnel vers d’autres établissements. L’Égypte, confrontée à un déficit en ressources humaines dans le secteur médical, souhaite ainsi optimiser l’utilisation de ses équipes tout en bénéficiant de partenariats étrangers.